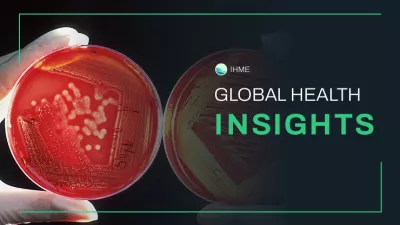
A Petri dish with bacterial cultures

Antimicrobial resistance (AMR)
AMR poses a major threat to human health around the world. AMR occurs when microorganisms, such as bacteria, adapt in ways that make currently available treatments for infections less effective.
Photo by CDC, Unsplash.
Key findings
Based on estimates for 204 countries and territories, IHME’s paper “Global burden of bacterial antimicrobial resistance 1990–2021: a systematic analysis with forecasts to 2050” reveals that AMR will continue to be a leading cause of death globally.
Nearly 5 million people who died suffered from AMR-related illness, such as a resistant lower respiratory or bloodstream infection, in 2021.
Over a million people are now dying each year solely because bacteria have become resistant to treatment (deaths directly attributable to resistance).

Deaths attributable to AMR are projected to reach nearly 2 million by 2050.
92 million infectious deaths (including both those involving AMR and those that are caused by a drug-susceptible pathogen) could be prevented between 2025 and 2050 through a combination of better health care for severe infections and access to antibiotics.

Inequalities across regions are significant.
Out of the 92 million deaths that could be averted through better health care for severe infections and access to antibiotics, many of them would be in sub-Saharan Africa and South Asia, underscoring inequalities across location.

AMR threatens health systems everywhere.
Use the MICROBE (Measuring Infectious Causes and Resistance Outcomes for Burden Estimation) tool to visualize the health estimates of infections, pathogens, and antimicrobial resistance across different geographies and time periods.

How do we combat AMR?
Bacteria are gaining resistance faster than new antibiotics can be developed, but decision-makers can use this information about AMR to inform development of new drugs or vaccines. Effective vaccines are particularly important since they would reduce the need for antibiotic use.
In the meantime, essential medicines need to be made accessible. In addition, more data is needed, particularly from lower-income countries; increasing high-quality tracking of AMR would bring greater clarity to this issue and empower doctors to make informed prescribing decisions in the clinic.
There are more immediate actions that can help countries around the world protect their health systems against the threat of AMR:
- Take greater action to monitor and control infections, globally, nationally and within individual hospitals.
- Accelerate our support for infection prevention and control, as well as expand access to vaccines and clean water and sanitation.
- Optimize our use of antibiotics unrelated to treating human disease, such as in food and animal production – taking a One Health approach and recognizing the interconnection between human and animal health.
- Be thoughtful about our use of antimicrobial treatments – expanding access to lifesaving antibiotics where needed, minimizing use where it is not necessary to improve human health, and acting according to the World Health Organization Global Action Plan and AWaRE guidelines.
- Increase funding at every stage of the development pipeline for new antimicrobials targeting priority pathogens – from research for high-priority bacteria, such as K. pneumoniae and E. coli, to securing access through innovative market solutions.
See the impact in your country
We developed individual country briefings on AMR for 204 countries and territories. These briefings are intended for key stakeholders working on AMR to help raise awareness of the real burden of antimicrobial resistance across different countries and regions.
Common questions about AMR
Antimicrobial resistance occurs when changes in bacteria or other pathogens cause the drugs used to treat infections to become less effective.
When antibiotics are misused or overused, resistance can develop. Lack of access to clean water, handwashing facilities, and general sanitation and hygiene increases the spread of pathogens, as does inadequate control and prevention of diseases in health care settings. In places where diagnostic capabilities (such as microbiology laboratories) are limited, it can be difficult to pinpoint the cause of an infection and which drugs will work best to combat it.
When first developed, antibiotics were a major breakthrough in medical science, providing reliable treatments for infectious diseases. But as organisms become resistant to drugs, we have fewer tools in our treatment toolbox. Some bacteria are already resistant to multiple drugs, and there are concerns about pathogens developing resistance to all current therapies. Such a “superbug” could spread unchecked through populations, potentially causing another global pandemic.
Various types of infections are caused by resistant bacteria, including infections of the lower respiratory tract, urinary tract, bloodstream, and abdomen.
Children under 5 years are at particular risk of acquiring an AMR infection because they interact with more unsanitary environments and have a less developed immune system. Elderly people, especially those with comorbidities, are similarly threatened. As AMR increases, more and more people will be at risk.